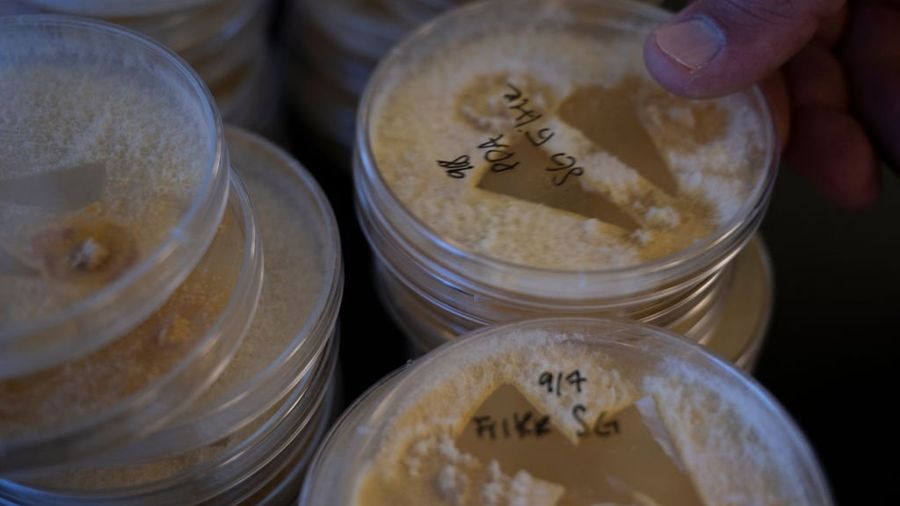

Suspect “admitted to smuggling the pathogen.”
June 03, 2025
Reprinted from Blaze Media
Federal authorities arrested two Chinese nationals after they were accused of attempting to smuggle a potential bioweapon into the United States, claiming they wanted to use it to conduct research at the University of Michigan.
On Tuesday, the Department of Justice announced charges against Yunqing Jian, 33, and her boyfriend, 34-year-old Zunyong Liu.
According to authorities, Liu arrived in the U.S. with a bag of fungus, Fusarium graminearum, which could be used as a potential agricultural terrorism weapon. The biological pathogen causes a devastating disease in wheat, barley, maize, and rice, the Detroit News reported.
RELATED: Rubio to ‘aggressively’ revoke Chinese nationals’ student visas to eviscerate CCP’s spy invasion
An FBI agent claimed in a criminal filing that Liu made “false statements” to Customs and Border Protection officers regarding his reason for visiting the U.S. and his knowledge of the fungus in his possession.
“Ultimately, Liu admitted to smuggling the pathogen and stated that he brought the pathogen into the United States so that he could conduct research on it at a laboratory at the University of Michigan where his girlfriend, Jian, worked,” the agent wrote.
Interim U.S. Attorney Jerome Gorgon stated, “The alleged actions of these Chinese nationals — including a loyal member of the Chinese Communist Party — are of the gravest national security concerns.”
“These two aliens have been charged with smuggling a fungus that has been described as a ‘potential agroterrorism weapon’ into the heartland of America, where they apparently intended to use a University of Michigan laboratory to further their scheme,” Gorgon added.
RELATED: Chinese national accused of voting in US election skips hearing, prompting bench warrant
The federal charges follow President Donald Trump’s crackdown on China’s infiltration of American universities.
Last week, Secretary of State Marco Rubio announced that the administration would implement new visa restrictions on Chinese students.
He wrote in a post on X, “The U.S. will begin revoking visas of Chinese students, including those with connections to the Chinese Communist Party or studying in critical fields.”